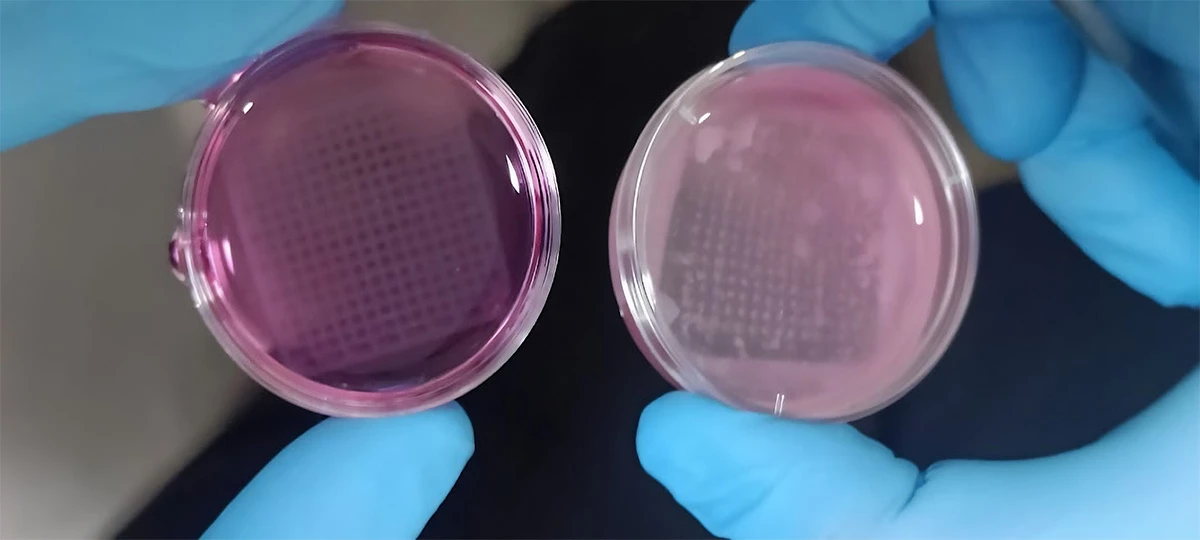

[ad_1]
While we’re making progress in phasing out animal testing in the cosmetics industry around the world, there’s still a ways to go in terms of regulatory measures (some 35 US states still allow it), international cooperation, and scientific advancements in developing reliable alternatives. 3D-printed ‘imitation skin’ could be the ticket.
Researchers from Austria’s Graz University of Technology and the Vellore Institute of Technology in India have developed a way to 3D print hydrogel formulations along with living skin cells, that eventually develop into tissue you can use to test new cosmetics.
A hydrogel is basically a synthetic equivalent of biological tissue that provides a flexible, water-containing matrix for living cells. In this application, the hydrogel needs to support the skin cells so they can and multiply. That’s tricky, because you also need the hydrogel to produce chemically and mechanically stable 3D prints.
That’s what the team in Austria is tasked with. The researchers in India, meanwhile, test the resistance and toxicity of the 3D prints in cell culture, and keep an eye on them over the two to three weeks it takes for them to develop into skin tissue.
Manisha Sonthalia / Vellore Institute of Technology
At this point, the tissue mimics the three-layer structure and biomechanics of human skin. The scientists note that they’re now ready to use their first batch of skin models in nanoparticle testing. If that works, and the team can further optimize the hydrogel formulations, it could likely be suitable for a range of cosmetics tests.
It’s worth noting that this research isn’t the only game in town. Cosmetics giant L’Oreal had already devised a way to reconstruct skin samples for testing purposes many years ago. The company even makes Episkin available to other companies for developing their own products. It was said to cost something like US$70 per sample all the way back in 2011.

In 2015, L’Oreal partnered with 3D-bioprinting firm Organovo to figure out a way to 3D print skin tissue. Last year, it claimed to have developed a 3D-printing method for reconstructed human skin, and presented its latest work in this niche at the VivaTech 2024 event in Paris.
Source: TU Graz
[ad_2]